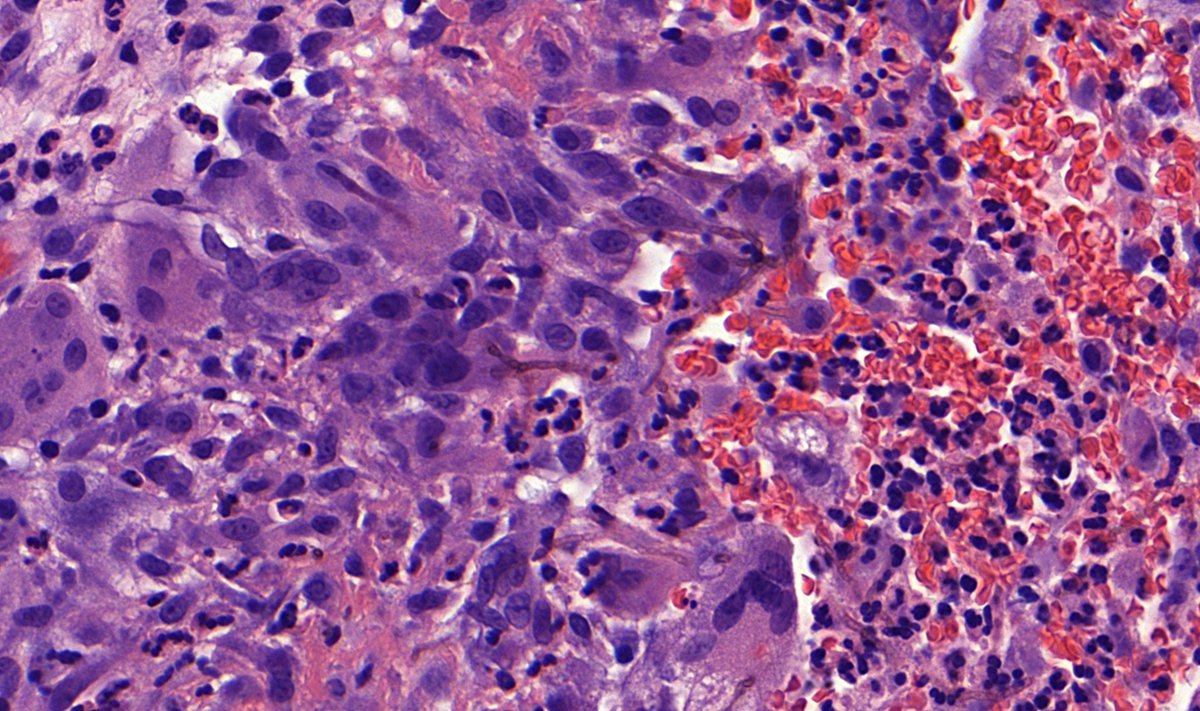
Lower leg, Male

#Dermpath #IDpath #Pathtwitter

Simon Roy MD
@simonroymd
Dermatopathologist I Yale Melanoma Research | Climbing, sourdough baking 👨🍳 Own views
ID: 999984092908261376
https://www.researchgate.net/profile/Simon_Roy2 25-05-2018 12:02:41
1,1K Tweet
1,1K Takipçi
917 Takip Edilen


Simon Roy MD Awesome #tweetorial 4 #dermpath #gynepath & #PathTwitter - not surprising as #tumor necrosis --> aggressive growth across many tumor types. It was a honour to work with Simon Roy MD and Vincent to bring attention to this gendered #melanoma that so far is not well studied!

#ISDP #Olympics Spot diagnosis Case 4 - Jose Candido EXTRAMAMMARY PAGET DISEASE Intraepithelial proliferation of cells with vesicular nuclei and basophilic/amphophilic cytoplasm. Cells distributed in a solitary fashion or in nest/gland-like structures #derm #path #med


.Meng Wang Hunter Shain iwei yeh @Ishanibanik1 UC San Francisco UCSF Helen Diller Family Comprehensive Cancer Ctr sequence #AcralMelanoma at different stages, find punctuated clusters of copy number alterations and specific driver mutation timing #CancerResearch Cancer at Nature Portfolio nature.com/articles/s4146…


Elizabeth McKenna We study epigenetics in cancer immunology at #Yale and we are hiring: miceviclab.github.io/postdoc-positi… #newPI



FRESH OFF THE PRESS - New study in European Society of Cardiology European Society of Cardiology Journals Prediction of incident atrial fibrillation using deep learning, clinical models and polygenic scores shows #AI can predict new-onset atrial fibrillation from ECGs with high accuracy, outperforming clinical and genetic


An honour to listen to Ruth Halaban Yale University, the first woman that graduated from Princeton University with a PhD degree in biology and recipient of the PASPCR lifetime achievement award, talk about the #LZTR1 gene and #melanoma